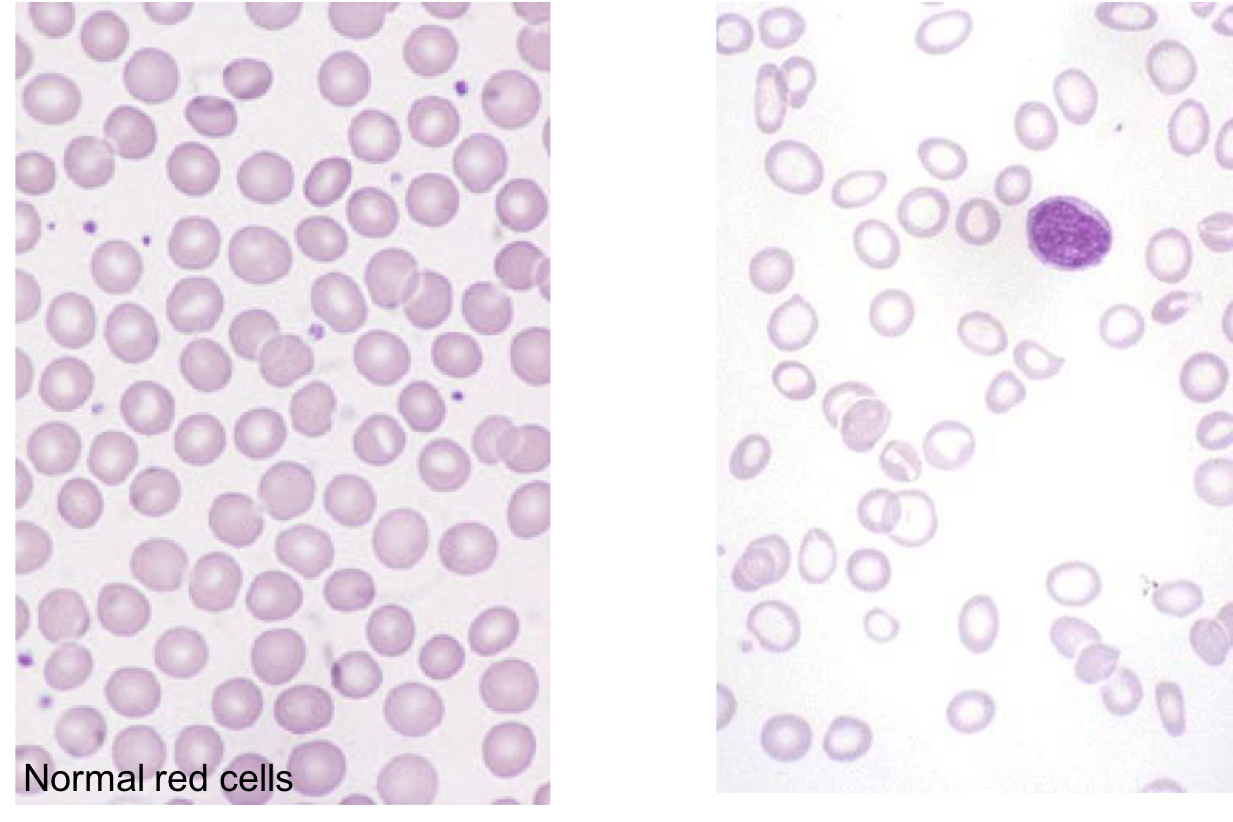

what are some factors influencing the normal range of haemaglobin?
Age
Sex
Ethnic origin
Time of day sample taken
Time to analysis
what are the Reference ranges of haemaglobin? (vary with age and sex)
- Male 12-70 (140-180)
- Male >70 (116-156)
- Female 12-70 (120-160)
- Female >70 (108-143)
As you get older there is a physiological drop in hemoglobin
Male different due to effect of testosterone
what are the clinical features of anaemia?
General features due to reduced oxygen delivery to tissues:
- Tiredness/pallor
- Breathlessness
- Swelling of ankles (degree of heart failure)
- Dizziness
- Chest pain
what do the lcinical features of anaemia depend upon?
Depend on age, speed of onset and Hb level
Will depend on a fall from the baseline that the patient is used to
what are some anaemia clinical features that are related ot the underlying cause?
Evidence of bleeding: Menorrhagia, Dyspepsia, PR bleeding
Symptoms of malabsorption - Diarrhoea, Weight loss
Jaundice
Splenomegaly/Lymphadenopathy
Anaemia Pathophysiology:
What is A

Cellularity
Stroma
Nutrients
Anaemia Pathophysiology:
What is B

Membrane
Haemaglobin
Enzymes
Anaemia Pathophysiology:
What is C

Blood loss
Haemolysis
Hypersplenism
Red cell indices - Automated measurement of red cell size and haemoglobin content
what are 2 important measurements?
MCH = Mean cell haemoglobin
MCV = Mean cell volume (cell size)
Can give a morphological description of anaemia – and a clue as to cause!!
what are the different morphological descriptions in anaemia?
Hypochromic – less colour
Microcytic – small
Small pale cells
Normochromic normocytic – normal amount of haemaglobin and on average they are a normal size. Many anaemias have this form. May have sickle cell and machine cant say what shape
Macrocytic – big red cells, usually less haemaglobin in them

what is shown here?
5 different patients
Don’t need to remember reference ranges
- Got bigger cells so got less cells and on average have more in it

What investigation is A?

serrum ferritin
Most common cause is Iron deficiency – do a serum ferritin
What investigation is B?

Reticulocyte count
Lots of causes so blood film important there to see what it looks like, reticulocyte count can be important, last stage of red cell development and if bleeding your reticulocyte count will go up to compensate and same in haemolysis. Reticulocyte count can be low in aplastic anaemia and tells if bone marrow is working or not
What investigation is C?

B12/FOlate
Bone Marrow
Commonest cause if B12/folate deficiency and if these are normal then may. Be a problem in the bone marrow
what is shown here?
Hypochromic, microcytic anaemia
Area of central pallor is about normal in the left photo
Right photo - RBC should be same size as a lymphocyte as seen in dark purple, more pale in the middle
in Hypochromic microcytic anaemia, if serum ferritin is low, then what is it likely to be?
iron deficiency
in Hypochromic microcytic anaemia, if serum ferritin is normal or increased, then what is it likely to be?
Thalassaemia
Secondary Anaemia
Sideroblastic anaemia (a disorder where the body produces enough iron but is unable to put it into the haemoglobin)
iron metabolism:
- Dietary intake ________ by loss
- Most of the body’s iron is in __ - And is “recycled”
Absorbed iron - bound to mucosal ______ and sloughed off Or transported across the basement membrane by ________
Then - bound to _________ in plasma
Stored as Ferritin - mainly in _____

balanced
Hb
ferritin
ferroportin
transferrin
liver

Ferratin is a measure of what?
iron stores
what is hepcidin?
Hepcidin synthesised in hepatocytes in response to ↑iron levels and inflammation – blocks ferroportin so reduces intestinal iron absorption and mobilisation from reticuloendothelial cells
(Transported from enterocytes and macrophages by ferroportin)
epcidin inhibits iron transport by binding to the iron export channel ferroportin
what is the Commonest cause of anaemia worldwide?
iron deficiency anaemia
Description not a diagnosis – establish cause!
what would appear in the history and examination of a patient with iron deficiency anaemia?
History:
- Dyspepsia, GI bleeding
- Other bleeding, eg menorrhagia
- Diet (NB children and elderly)
- Increased requirement - pregnancy
Examination:
- Signs of iron deficiency
- Abdominal and rectal
what are clinical features of iron deficiency?

what are the causes of iron deifiency?
GI blood loss
Menorrhagia (menstrual periods with abnormally heavy or prolonged bleeding)
Malabsorption:
- gastrectomy
- coeliac disease










